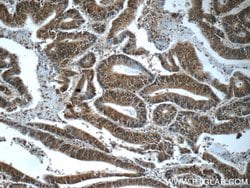
HDAC10 Rabbit anti-Human, Mouse, Rat, Polyclonal, Proteintech 150 &mu;L;
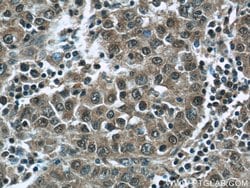
HDAC10 Rabbit anti-Human, Mouse, Rat, Polyclonal, Proteintech 150 &mu;L;

missing translation for 'onlineSavingsMsg'
Learn More
Learn More
HDAC10 Rabbit anti-Human, Mouse, Rat, Polyclonal, Proteintech
Rabbit Polyclonal Antibody
Brand: Proteintech 24913-1-AP-150UL
This item is not returnable.
View return policy
Description
Responsible for the deacetylation of lysine residues on the N-terminal part of the core histones (H2A, H2B, H3 and H4). Histone deacetylation gives a tag for epigenetic repression and plays an important role in transcriptional regulation, cell cycle progression and developmental events. Histone deacetylases act via the formation of large multiprotein complexes.Specifications
| HDAC10 | |
| Polyclonal | |
| Unconjugated | |
| HDAC10 | |
| HD10, HDAC10, histone deacetylase 10 | |
| Rabbit | |
| Antigen Affinity Chromatography | |
| RUO | |
| 170787, 362981, 83933 | |
| -20°C | |
| Liquid |
| Immunocytochemistry, Immunofluorescence, Immunohistochemistry (Paraffin), Western Blot | |
| 0.43 mg/mL | |
| PBS with 50% glycerol and 0.1% sodium azide; pH 7.3 | |
| Q569C4, Q6P3E7, Q969S8 | |
| Hdac10 | |
| HDAC10 Fusion Protein Ag18470 | |
| 150 μL | |
| Primary | |
| Human, Mouse, Rat | |
| Antibody | |
| IgG |
Product Content Correction
Your input is important to us. Please complete this form to provide feedback related to the content on this product.
Product Title
Spot an opportunity for improvement?Share a Content Correction